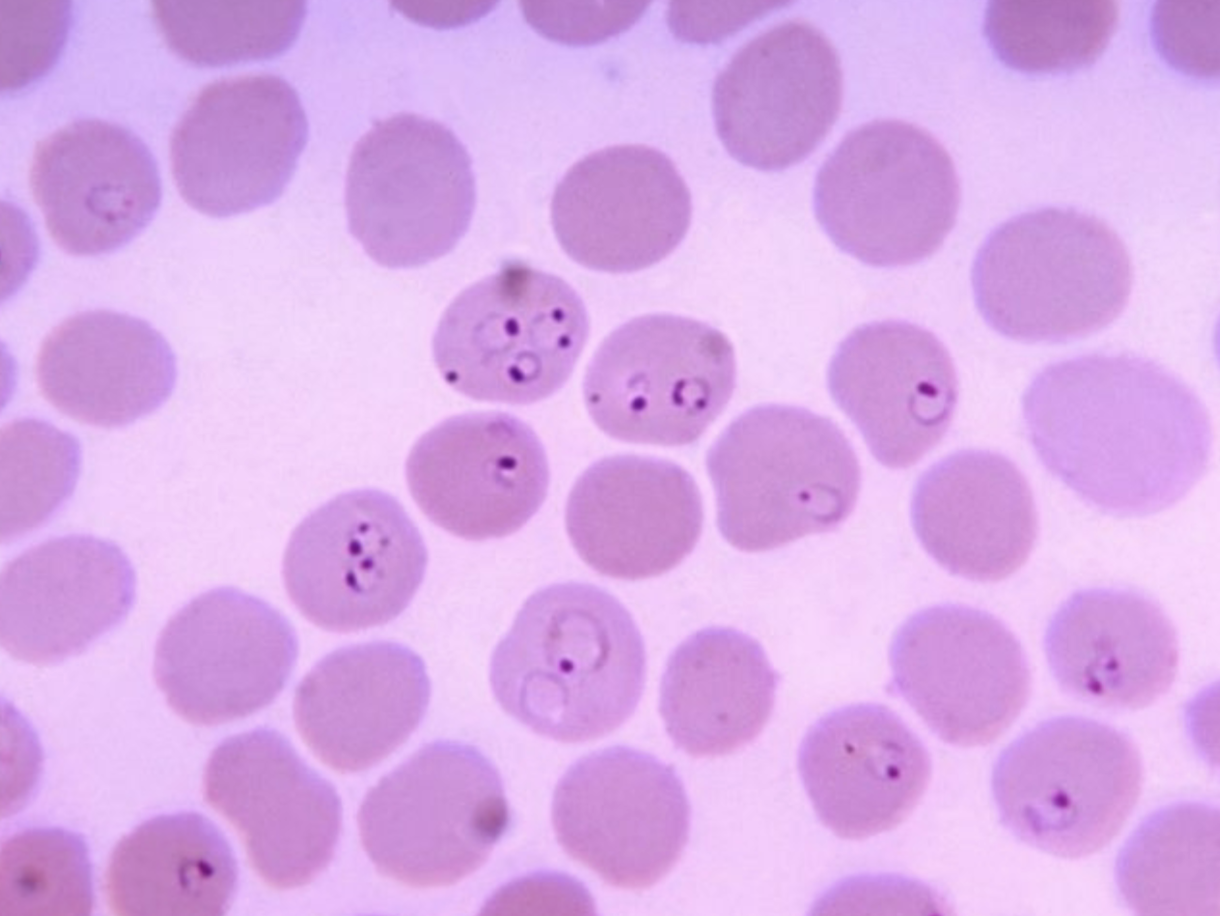
<p>What protist is this? (genus name)</p>

1/120
Looks like no tags are added yet.
Name | Mastery | Learn | Test | Matching | Spaced | Call with Kai |
|---|
No analytics yet
Send a link to your students to track their progress

What is this protist? (genus name)
Euglena
What structure allows Euglena to swim?
Flagellum
What organelles do Euglena have that performs photosynthesis?
Chloroplasts
Whats the purpose of chloroplasts in photosynthesis?
converting solar energy into chemical energy (glucose) using water and carbon dioxide

What protist is this? (genus name)
Paramecium
What structures does paramecium have that allows it to swim?
Cilia

What protist is this? (genus name)
Amoeba or Ameba
what structure do Amoeba (or Ameba) use to move
pseudopodia allows for crawling
Whats the mechanisms for pseudopodia?
amoeboid movement, involving the extension of the membrane and the shifting of endoplasm (inner cytoplasm) toward the front

Whats this protists name? (genus name)
Leishmania

Whats this protists name? (genus name)
Leishmania
Whats the clinical name of the disease Leishmania causes.
leishmaniasis
How could a human get infected by leishmania?
sandfly bites human and injects saliva
Side effects of leishmaniasis
Cutaneous - skin sores, visceral - internal organs, and mucosal - spreads to mucous membranes of nose, mouth, and throat
structure that allows Leishmania to move
Flagellum
Where does leishmania live in sandflies?
digestive system
What species do trypanosoma live in?
bloodsucking bugs
How do bloodsucking bugs transmit trypanosoma in humans?
when they feed they defecate and the person rubs the feces into their eye wound.

What protists is this? (genus name)
trypanosoma
How does trypanosoma move?
flagellum
How do humans get infected with trichomonas?
mutual consent (STI)

What protist is this?
Trichomonas
What disease is caused by trichomonas?
trichomoniasis (STI)
How do trichomonas move?
flagellum

What protist is this? (genus name)
Giardia cyst
Where are the Giardia cyst shed?
in host feces
Do Giardia cyst cause symptoms?
No
WHat type of form are Giardia cysts?
infective

What protists is this? (genus name)
Giardia trophozoites
How do Giardia trophozoites move?
flagellum
Why are Giardia trophozoites no infective?
they die quickly outside host
Where for Giardia trophozoites inhabit in host?
small intestine
What do symptoms do Giardia trophozoites cause?
GI symptoms like gas or diarrhea
How do humans get infected by Entameba?
ingesting its cyst form usually in fecally-contaminated food or water

What is this protist? (genus name)
Entameba cyst
What disease does Entameba cause?
amebiasis or amoebic dysentery
where does Entameba infect in humans?
intestines
Where are entameba cyst shed?
in hosts feces
what do Entameba use to move?
pseudopods
What causes symptoms relating to Entameba cysts?
trophozoites
What stage are entameba cysts?
infective
What can entameba cause in the human body?
abscesses and ulcerate intestinal lining

What protist is this? (genus name)
Balantidium trophozoite
what stage of Balantidium is infective when ingested?
cyst stage
What disease does Balantidium trophozoite cause?
Balantidiasis
What cause the symptoms of balantidiasis?
trophozoites
what structure do Balantidium trophozoite use to move?
cilia
Are Balantidium trophozoites infective?
no because they do not live long outside the host
What protist is this? (genus name)
Plasmodium
What disease does Plasmodium cause?
malaria
What disease has killed more humans than any other?
malaria
How are Plasmodium transmitted?
female mosquitoes feed on blood and transfer from person to person

What type of parasitic worm is this?
fluke eggs or fasciola hepatica egg
Where are fluke eggs or fasciola hepatica egg found?
in water
How do fluke eggs or fasciola hepatica egg end up in eater?
expelled in feces of an infected host

what fluke is this?
Fasciola hepatica miracidia, larval slukes

What stage is this fluke at?
miracidium

Whats the name of this fluke?
Fasciola hepatica miracidia
True or False: Fasciola hepatica miracidia are what hatch out of the eggs
true
Where are Fasciola hepatica miracidia found?
swimming in water
After hatching, how long do Fasciola hepatica miracidia last?
8 hours
What color are Fasciola hepatica miracidia stained?
red, blue-green, or purple
Whats the shape of Fasciola hepatica miracidia?
roughly bullet-shaped
Whats the width of Fasciola hepatica miracidia?
a microscopes pointer when viewed using 10X objective

What fluke is this?
Fasciola hepatica miracidia

What fluke is this?
Fasciola hepatica redia larva

What stage is this fluke relating to the fluke life cycle?
larval
Where are Fasciola hepatica redia larva found?
body of the appropriate host snail (intermediate host)

What was the red objects inside this fluke?
developing cercariae inside the redia

What fluke is this?
Fasciola hepatica cercaria

What stage of the fluke life cycle is this fluke at?
cercaria (larval)
Where are Fasciola hepatica cercaria found?
swimming in water after leaving the snail

What fluke is this?
Fasciola hepatica metacercaria

What stage is this fluke at in the fluke life cycle?
metacercaria (larval)
Where are Fasciola hepatica metacercaria found?
on aquatic plants like watercress or cattails
How long do Fasciola hepatica metacercaria remain in the metacercaria (larval) stage?
until they die or until a host like a human eats the plant

What fluke is this?
An adult fasciola hepatica
What type of reproductive system do adult fasciola hepatica have?
hermaphroditic
Where are adult fasciola hepatica found?
in liver and bile ducts of definitive host
true or false: adult fasciola hepatica eggs shed in the hosts feces
true

What fluke is this?
adult fasciola hepatica

What fluke is this?
adult fasciola hepatica

What parasitic worm/fluke is this?
Schistosoma mansoni adults (male and female)
how are Schistosoma mansoni adults found?
coupled when in intestinal blood vessel, liver tissue, or intestinal wall of human
which Schistosoma mansoni adult is large the male or female?
male
About how many people worldwide are affected by Schistosoma mansoni?
240 million
Whats the definition of hermaphroditic?
a worm that has both ovaries and testes.

What parasitic worm is this?
tapeworm eggs
What are tape worms definitive host?
intestines
what are tapeworms intermediate hosts?
muscle or viscera of host
Where do tapeworm eggs shed?
feces of tapeworm definitive host
Where a tapeworm eggs sometimes encased in?
proglottids

What parasitic worm is this?
tapeworm eggs

What parasitic worm is this?
tapeworm cysticercus larva
Whats the genus name is tapeworm cysticercus larva?
Taenia pisiformis cysticercus
Where are tapeworm cysticercus larva located?
muscle or viscera of intermediate host

What stage is this parasitic worm at?
larval

What parasitic worm is this?
tapeworm cysticercus larva.

What parasitic worm are these?
mature tapeworm proglottids

What are the brown lines in this tapeworm proglottids?
fertilized eggs in gravid proglottids